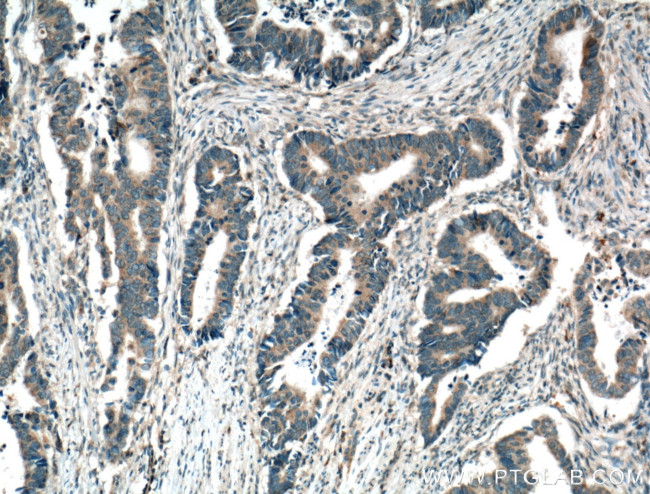
ARK5 Antibody in Immunohistochemistry (Paraffin) (IHC (P))

Search
Proteintech
ARK5 Polyclonal Antibody
{{$productOrderCtrl.translations['antibody.pdp.commerceCard.promotion.promotions']}}
{{$productOrderCtrl.translations['antibody.pdp.commerceCard.promotion.viewpromo']}}
{{$productOrderCtrl.translations['antibody.pdp.commerceCard.promotion.promocode']}}: {{promo.promoCode}} {{promo.promoTitle}} {{promo.promoDescription}}. {{$productOrderCtrl.translations['antibody.pdp.commerceCard.promotion.learnmore']}}
产品信息
22723-1-AP
种属反应
已发表种属
宿主/亚型
分类
类型
抗原
偶联物
形式
浓度
规格
纯化类型
保存液
内含物
保存条件
运输条件
产品详细信息
Immunogen sequence: HSLSCRRKG ILKHSSKYSA GTMDPALVSP EMPTLESLSE PGVPAEGLSR SYSRPSSVIS DDSVLSSDSF DLLDLQENRP ARQRIRSCVS AENFLQIQDF EGLQNRPRPQ YLKRYRNRLA DSSFSLLTDM DDVTQVYKQA LEICSKLN (515-662 aa encoded by BC152462)
靶标信息
NUAK1 (ARK5) is a serine/threonine kinase that plays a role in many cellular functions. The overexpression of this kinase has been associated with tumor invasion and metastasis (colorectal neoplasm). Acts as a regulator of cellular senescence and cellular ploidy by mediating phosphorylation of 'Ser-464' of LATS1, thereby controlling its stability. Controls cell adhesion by regulating activity of the myosin protein phosphatase 1 (PP1) complex. Acts by mediating phosphorylation of PPP1R12A subunit of myosin PP1: phosphorylated PPP1R12A then interacts with 14-3-3, leading to reduced dephosphorylation of myosin MLC2 by myosin PP1. May be involved in DNA damage response: phosphorylates p53/TP53 at 'Ser-15' and 'Ser-392' and is recruited to the CDKN1A/WAF1 promoter to participate in transcription activation by p53/TP53. May also act as a tumor malignancy-associated factor by promoting tumor invasion and metastasis under regulation and phosphorylation by AKT1. Suppresses Fas-induced apoptosis by mediating phosphorylation of CASP6, thereby suppressing the activation of the caspase and the subsequent cleavage of CFLAR. Regulates UV radiation-induced DNA damage response mediated by CDKN1A. In association with STK11, phosphorylates CDKN1A in response to UV radiation and contributes to its degradation which is necessary for optimal DNA repair.
仅用于科研。不用于诊断过程。未经明确授权不得转售。
生物信息学
蛋白别名: AMP-activated protein kinase family member 5; AMPK-related protein kinase 5; ARK5; NUAK family SNF1-like kinase 1; NUAK family, SNF1-like kinase, 1; Omphalocele kinase 1; unnamed protein product; ZNUAK family, SNF1-like kinase, 1
基因别名: ARK5; AU014801; AW494241; B230104P22Rik; KIAA0537; NUAK1; OMPHK1; RGD1309956
UniProt ID: (Human) O60285, (Mouse) Q641K5
Entrez Gene ID: (Human) 9891, (Rat) 299694, (Mouse) 77976